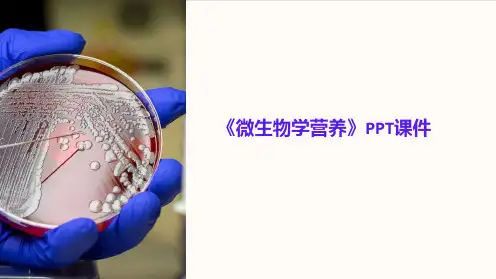

基本营养物质的培养基。
例如:牛肉膏蛋白胨培养基(细菌)
牛肉膏 蛋白胨 NaCl 琼脂 水 PH
3g 10g 5g 18--20g 1000ml 7.0----7.2
培养基
(2)加富培养基(enrichment medium)
又叫营养培养基
定义:在基础培养基中加入某些特殊营养物 质制成的营养丰富的培养基。
[CH2O] + O2 ↑
如以还:绿 原硫 态细 无菌 机、硫紫化硫物细作菌氢或还电原子C供O体2 时。,
光能
CO2 + 2H2S 细→菌 [CH2O] + H2O + 2S
叶绿素
微生物的营养类型
(2)光能有机营养型(photorganotroph)
又叫异养微生物。又称光能异养型微生物。 红螺菌属.
脂肪酶
脂肪
甘油 +O2 CO2+H2O
脂肪酸 -O2 简单酸+CO2+CH4
应用:屠宰场;生活污水。
3 果胶物质的分解
原果胶酶
原果胶+H2O
可溶性果胶+多缩戊糖
可溶性果胶+H2O 果胶甲基酯酶 果胶酸+甲醇
果胶酸+H2O 多缩半乳糖酶 半乳糖醛酸
应用:麻类物质的脱胶处理
水浸——厌氧性细菌 露浸——好氧性细菌、放线菌、真菌
定义:以小分子有机物为最终电子受体的生物 氧化过程。有机物为呼吸基质的中间产物。
最终电子受体——有机物 参与的微生物——厌氧菌和兼性厌氧菌。 不经过电子传递体。 常见的发酵有
§乙醇发酵 §乳酸发酵
§丁酸发酵
乙醇发酵(生产酒精)
葡萄糖
3-磷酸甘油醛
2NAD
乙醇
1,3-二磷酸甘油酸
2NADH2